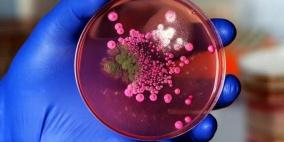

الطقس
Loading...
أوقات الصلاة
| الفجر | 4:38 AM |
| الظهر | 12:38 PM |
| العصر | 4:15 PM |
| المغرب | 7:18 PM |
| العشاء | 8:38 PM |
العملات
Loading...
ترددات البث
| جنوب فلسطين | FM 96.8 |
| أريحا و الأغوار | FM 96.8 |
| وسط فلسطين | FM 98.3 |
| جنين و الخليل | FM 98.3 |
| شمال فلسطين | FM 96.4 |